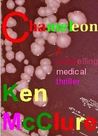
Chameleon cover

Affiliate Disclosure: Links on this page may earn us a commission at no extra cost to you. Read our affiliate policy
Ken McClure Books in Order
Ken McClure is a renowned author of internationally bestselling medical thrillers, with a diverse portfolio that includes The Lazarus Strain, The Gulf Conspiracy, White Death, and Dust to Dust. His gripping stories have captivated readers worldwide, with translations in twenty-five languages. McClure's expertise is rooted in his distinguished career as an award-winning research scientist with the UK's Medical Research Council, where he brought a unique level of authenticity to his writing. His work is marked by meticulous research and an uncanny ability to predict the most complex medical scenarios, earning him a reputation as a master of the genre. McClure resides in a picturesque village in the Lammermuir Hills of Scotland, where he continues to draw inspiration for his thought-provoking and suspenseful novels.
Bibliography verified: March 2026
Quick Answer
What are all of Ken McClure's book series? Ken McClure has written 2 book series. The most notable is the Dr. Steven Dunbar series.
Complete series list with all books in reading order below.
Book Series by Ken McClure
- #1
 Donor(1999)
Donor(1999) - #2
 Deception(2001)
Deception(2001) - #3
 Wildcard(2002)
Wildcard(2002) - #4
 The Gulf Conspiracy(2004)
The Gulf Conspiracy(2004) - #5
 Eye of the Raven(2005)
Eye of the Raven(2005) - #6
 The Lazarus Strain(2007)
The Lazarus Strain(2007) - #7
 White Death(2009)
White Death(2009) - #8
 Dust to Dust(2010)
Dust to Dust(2010) - #9
 Lost Causes(2011)
Lost Causes(2011) - #10
 The Secret(2013)
The Secret(2013) - #11
 The Devil's Landscape(2017)
The Devil's Landscape(2017) - #12
 Miasma(2019)
Miasma(2019)
- #1
 The Anvil / Anvil Agreement(1985)
The Anvil / Anvil Agreement(1985) - #2
 The Scorpion's Advance(1986)
The Scorpion's Advance(1986) - #3
 The Trojan Boy(1988)
The Trojan Boy(1988) - #4
 Fenton's Winter(1989)
Fenton's Winter(1989) - #5
 Pestilence(1991)
Pestilence(1991) - #6
 Requiem(1992)
Requiem(1992) - #7
 Crisis(1993)
Crisis(1993) - #8
Chameleon(1994)
Chameleon(1994) - #9
 Trauma(1995)
Trauma(1995) - #10
 Pandora's Helix(1996)
Pandora's Helix(1996) - #11
 Resurrection(1999)
Resurrection(1999) - #12
 The Tangled Web(2000)
The Tangled Web(2000) - #13
 Past Lives(2006)
Past Lives(2006) - #14
 Hypocrites' Isle(2009)
Hypocrites' Isle(2009) - #15Full-time writing didn’t come into the picture until 2000.(20)
About Ken McClure
Ken McClure is a renowned author of internationally bestselling medical thrillers, with a diverse portfolio that includes The Lazarus Strain, The Gulf Conspiracy, White Death, and Dust to Dust. His gripping stories have captivated readers worldwide, with translations in twenty-five languages. McClure's expertise is rooted in his distinguished career as an award-winning research scientist with the UK's Medical Research Council, where he brought a unique level of authenticity to his writing. His work is marked by meticulous research and an uncanny ability to predict the most complex medical scenarios, earning him a reputation as a master of the genre. McClure resides in a picturesque village in the Lammermuir Hills of Scotland, where he continues to draw inspiration for his thought-provoking and suspenseful novels.
Affiliate Disclosure
As an Amazon Associate, Reading Order Books earns from qualifying purchases. When you buy through links on our site, we may earn an affiliate commission at no additional cost to you. This helps us maintain the site and continue providing reading order guides. Read our full disclosure